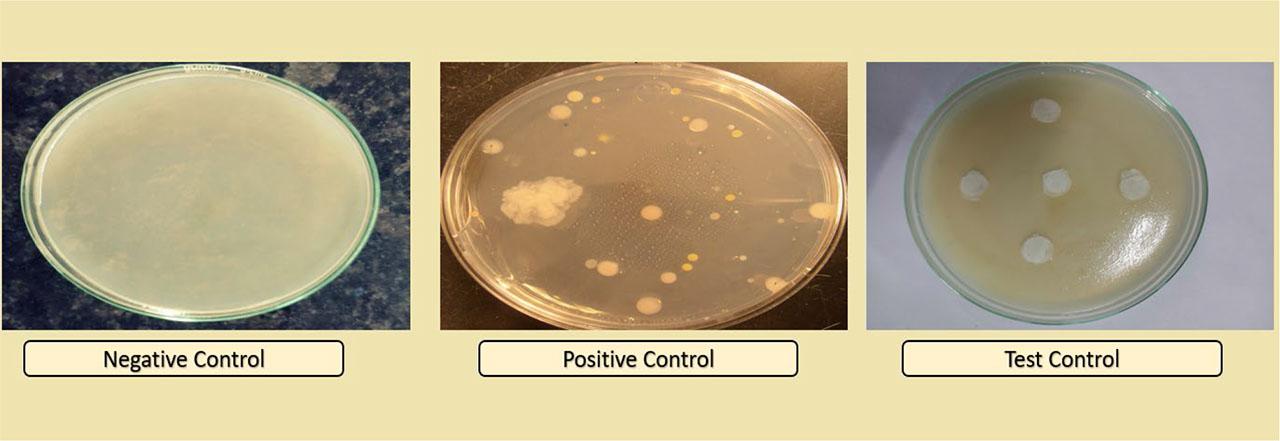

Glaucoma is a type of pathological condition which is characterized by an increase in the intraocular pressure, resulting in temporary or permanent damage to the eye if not treated timely. Glaucoma is the second major leading cause of the blindness worldwide and affects over 76 million people worldwide, which is estimated to increase to 112 million by 2040 (Tham et al., 2014) and nearly 2–3 million people in America suffer annually (Zhang et al., 2024). The prevalence rate of glaucoma in India was found to be 2.7–4.3% in 2008 (Vijaya et al., 2008), and over the years, it is responsible for causing 5.5% of total irreversible blindness among Indian people (Vashist et al., 2022). On one hand, open angle glaucoma is the most common type of glaucoma, which damages the optic nerve and reduces vision and even blindness. On the other hand, in closed angle glaucoma, the iris blocks the drainage angle in eye which results in high pressure inside eye (Jayaram et al., 2023).
Glaucoma contributes over $3 billion to an annual economic burden in the United States alone, while in Europe, it is estimated to be €1.5 billion annually (Lazcano et al., 2016). Nonadherence to glaucoma treatment schedules is still a significant challenge, with up to 50% of patients failing to consistently follow therapies. Moreover, long medication schedules, cost of treatment, and side effects of medicines further increase the complexity of treatment. These issues highlight the need for more research studies so that sustained-release drug delivery systems can be explored, which can reduce the socioeconomic burden (Varma et al., 2011).
Currently, medicated eye drops for glaucoma are available in the market but have major challenges such as drug loss while blinking of eyes, lesser bioavailability, lacrimation, frequent dosing, lesser penetration, lesser stability, and uncontrolled drug release (Paganini et al., 2024). Literature reports that nearly 37% of the patients, treated with eye drops, did not follow the prescribed frequency of dosing. This nonadherence of prescribed treatment further results in increased damage in eyes (Kavitha et al., 2024).
To address all these issues, various research studies are going on to prepare different ocular novel drug delivery systems (NDDS) like gels, ointments, emulsions, suspensions, ocuserts, and films, as an alternative for eye drops. Ocuserts are semi-solid dosage forms which can be prepared by using natural, synthetic, or semi-synthetic polymers (Lu et al., 2024). Ocuserts can be placed in the cul-de-sac cavity of the eyes in either upper or lower side. As the polymeric system gradually degrades, the drug contained within the ocuserts is released in a controlled manner to the target site of action (Fu et al., 2010). This reduces the frequent dosing as in eye drops and increases patient compliance. Despite of such major advantages, few disadvantages of ocuserts are that some patients found it difficult to insert and remove the ocuserts from eyes, and moreover, if it is not positioned correctly, there are chances of its dislocation and loss. Other than this, the cost of ocuserts is higher than that of traditional dosage forms, making it not widely adopted by ocular patients (Razavi et al., 2022).
Among multiple antiglaucoma drugs, brimonidine tartrate (BT) is chosen due to its dual mechanisms of action. It not only reduces the production of aqueous humor but also increases the outflow of the aqueous humor from eyes. BT is a white to off-white crystalline powder, which is freely soluble in water and alcohol. It is moderately soluble in organic solvents like methanol. It has the molecular weight of 442.3 g/mol and a reported melting point of 154–156°C. Its log P-value is approximately 2.5, which indicates that the drug is moderately lipophilic in nature as well. The pKa value of drug is 7.5, which specifies that it exists as protonated form at physiological pH (7–7.5). All these properties are suitable for the use of BT as ophthalmic preparations. Currently, it is marketed under various brand names and as generic preparations (Bakheit et al., 2023). BT is marketed as ophthalmic solutions in 0.1% and 0.2% w/v under well-known brand Alphagan® (Allergan) to treat primary open angle glaucoma and ocular hypertension. Other than this, various other generics are available in market with same concentrations, viz., Apotex, Sandoz, Teva, Amgen, Mylan. BT is also marketed in combination with other antiglaucoma drugs like timolol maleate. The fixed dose combination of BT 0.2% w/v and timolol maleate 0.5% w/v is marketed under brand name Combigan® (Allergan).
Different polymers are employed for ocular delivery, but few of these have certain disadvantages, such as chitosan (limited hydrophilicity, high viscosity) (Gu et al., 2025), polycaprolactones (slow degradation rate and low hydrophilicity) (Taghe et al., 2024), hydroxypropyl methylcellulose (HPMC) (blurry vision and eye redness) (Zhao et al., 2024), carbomer (compatibility issues and stinging in eyes) (Rahbar et al., 2024), methyl cellulose (limited drug release control and blurred vision) (Vijayaraghavan et al., 2024), polyethylene glycol (susceptible to allergic reactions and hydration effect) (Kleinman et al., 2024), sodium alginate (blurred vision and limited stability) (Hu et al., 2024), and polyvinyl alcohol (limited drug release control and eye dryness) (Das et al., 2025). On the other hand, PLGA is a Food and Drug Administration (FDA)-approved polymer, which is also proven to have the property of increasing the penetration of the drug in eyes (Zhi et al., 2021). Its biodegradable nature eliminates the requirement of removal of ocuserts from the eyes. Moreover, PLGA is found to have the ability to encapsulate both hydrophobic and hydrophilic drugs (Huang et al., 2024). The degradation rate of PLGA can be controlled by modification in lactide-to-glycolide ratio. PLGA also exhibits biocompatibility which further reduces the risk of irritation and adverse reactions.
In current research work, BT-loaded PLGA ocuserts were prepared using two methods: solvent casting method (SCM) and glass substrate method (GSM). Other than these two methods, melt extrusion technique (MET) is also reported to prepare ocuserts. MET requires organic solvents for preparation of ocuserts, which further increases the probability of irritation in eyes (Shadambikar et al., 2021). Moreover, as the name indicates, MET requires the melting of all polymeric materials, drugs, and other substances of ocuserts at initial stage of processing, which make this process unsuitable for the thermolabile substances. PLGA, BT, and other substances used in the preparation of ocuserts are thermolabile in nature, and hence, the methodology of MET was not used to prepare ocuserts. Hence, SCM and GSM were selected for this study due to their proven ability to fabricate polymeric ocuserts with controlled drug release profiles. Unlike MET, which involves high temperatures unsuitable for thermolabile drugs, or electrospinning, which requires specialized equipment, SCM and GSM provide feasible alternatives for sustained ocular drug delivery. While GSM allows for greater sterility control, SCM enables better scalability, making it more relevant for industrial applications. As per the reports, SCM can be considered as a cost-effective method because long polymeric films can be prepared with an increase in polymer concentrations. SCM is easier to scale, particularly for large-scale production in pharmaceutical industries. However, it requires careful control while drying and solvent handling. However, maintenance of controlled environment is necessary to upkeep the sterility of film during large-scale production. On the other hand, GSM is a suitable method for high-precision, small-scale applications, and maintenance of sterility is also feasible due to its small-scale applications (Vecchi et al., 2021).
Brimonidine tartrate was received as a gift sample from the FDC Private Limited, Haryana, India. PLGA polymer (with a lactide:glycolide ratio of 50:50) was purchased from the Nomisma Healthcare Private Limited, Gujarat, India. Chemicals like propylene glycol, glycerol, and acetone with 99.5% v/v analytical reagent (AR) were taken from LOBA Chemie Private Limited, Mumbai, India. Dialysis membrane number 150 was purchased from HiMedia laboratories, Mumbai, India. All the other ingredients like sodium hydroxide, hydrochloric acid, dibutyl phthalate, glycerine, acetic acid, and hydroxypropyl methyl cellulose (HPMC) were purchased from Sigma Chemical Corporation, Missouri, USA.
The BT-loaded PLGA ocuserts were prepared using three different steps (Kumar et al., 2022).
Accurately weighed 50 mg of BT was dissolved in 20 ml of freshly prepared acetic acid solution (1%); 50 mg of PLGA was dissolved in this acetic acid solution to maintain the drug:polymer ratio as 1:1. The solution was allowed to dissolve under magnetic stirrer at room temperature (100 rpm) till a clear solution received. 20 ml of HPMC solution (2%) was added in this clear solution and allowed to stir, and 1 ml of dibutyl phthalate (act as a plasticizer) was added. The pH of final prepared solution was maintained to 7.4 using 1 % of sodium hydroxide and hydrochloric acid solutions. The complete prepared solution was poured in a petri dish which was previously sterilized with the help of the ethanol:acetone (60:40) and was further lubricated by glycerine (Navneet et al., 2023). This lubrication is important to take out the dried film smoothly after evaporation of liquid. The dried membrane was further cut into the 8-mm-sized spherical shaped pieces with the help of stainless-steel borer, which was previously sterilized using ethanol:acetone (60:40) (Devhadrao et al., 2018).
About 2 g of ethyl cellulose was dissolved in 20 ml of acetone and was further allowed to stir with magnetic stirrer until a clear solution is obtained. This solution was added in the petri dish, which was previously sterilized with the help of ethanol:acetone (60:40) and was lubricated with the help of a glycerine as we performed in Step 1. After drying, the film was cut into the 10-mm-sized spherical shaped pieces with help of a stainless-steel borer which was previously sterilized as described in Step 1 (Abdul et al., 2011).
The sealing of the RCM and DRM membranes were performed under desiccator, which was previously sterilized with solution of ethanol:acetone (60:40). The medicated DRM was sandwiched between the two RCMs and allowed to get sealed after drying. Figure 1 shows this as different layers of ocuserts. The sealed ocuserts were taken out from the desiccator after 24 hours and were further assessed for different evaluation tests. The ocuserts prepared by this method were labeled as SCM ocuserts. All above steps were carried out in sterile room under laminar airflow, in order to maintain the sterility of prepared ocuserts (Parastoo et al., 2017).

Different layers of ocuserts.
Accurately weighed 50 mg of BT was dissolved in a beaker containing 20 ml of 1 % acetic acid solution, and 50 mg of PLGA was dissolved in this acetic solution to maintain drug:polymer concentration in ratio of 1:1. The complete solution was mixed well using magnetic stirrer at room temperature with 100 rpms till a clear solution was obtained. The solution was vortexed to remove any air bubbles; and 20 ml of 2 % HPMC solution was mixed with the above-prepared acetic acid solution and allowed to get uniformly mixed using magnetic stirrer for 30 min. 1 ml of dibutyl phthalate was added in the solution mixture as plasticizer (Sarath et al., 2010).
pH of the above solution was maintained to 7.4 with the help of 1 % of hydrochloric acid and sodium hydroxide solution. After this, a glass mold was taken, which was previously sterilized by ethanol:acetone (60:40). After applying a layer of the glycerine on the glass mold, the prepared solution was carefully poured in glass mold. Later, the solution was allowed to dry in room temperature. After 24 hours, the dried film was taken out with the help of a spatula, which was already sterilized. Later, the film was cut into the circular special shapes of 8 mm size. The ocuserts prepared by this method were labeled as GSM ocuserts (Sarath et al., 2010). All above steps were carried out in a sterile room under laminar airflow in order to maintain the sterility of prepared ocuserts.
In terms of scalability for industrial production, SCM can be considered as more cost-effective method than GSM for large-scale production in pharmaceutical industries. However, sterile environment is required to maintain during large-scale production. On the other hand, GSM limit its use as mainly involved in small-scale manufacturing (Sarkar et al., 2025 and Farahmandnejad et al., 2024) However, it is more suited for high-precision requirements maintaining its sterility in controlled environments.
The prepared SCM and GSM ocuserts were evaluated for color, shape, texture, roughness, and surface smoothness (Parastoo et al., 2017).
The prepared SCM and GSM ocuserts were allowed to swell for 1 hour in 10 ml of double distilled water. The swollen ocuserts were further tested for pH using calibrated digital pH meter (Rahic et al., 2020).
The thickness of SCM and GSM ocuserts were calculated using calibrated Vernier caliper, which has the least count of 0.01 mm. The thickness of ocuserts was calculated from five different spots (one from center and the rest four from surroundings). The mean of the readings represents the thickness of the single ocusert (Nair et al., 2018).
The folding endurance studies are important to understand the ability of ocuserts to withstand repeated folding without breaking, cracking, or losing functionality. Ideal ocuserts must maintain its structural integrity to ensure consistent drug release. A high folding endurance indicates that ocusert can retain its shape and deliver the drug over extended period. If the folding endurance is low, then cracks or tears appears in ocuserts, which can affect the drug release and ultimately lead to low therapeutic effectiveness. Therefore, optimal folding endurance is critical for ocuserts. Prepared SCM and GSM ocuserts were folded from the center by putting it between fingers and thumb and was then unfolded. One full fold and unfold represents 1 folding of ocusert. This process was repeated until the ocusert either break into pieces or visible cracks can be identified on the surface of ocuserts (Mealy et al., 2014).
The prepared SCM and GSM ocuserts were weighed individually using calibrated digital analytical balance (calibration was done using standard weights) (Rahic et al., 2020).
Swelling index is an important parameter to determine the moisture absorbing capacity of ocuserts from environment during its transport and storage. Films with a high swelling index can absorb more moisture which can alter the drug release pattern from ocuserts. On the other side, the ocuserts with low swelling may dry out at faster rate (Farahmandnejad et al., 2024). The prepared SCM and GSM ocuserts were initially weighed and then further placed in phosphate buffer of pH 7.4 for 24 hours. The swollen ocuserts were taken out and re-weighed (Revathy et al., 2015). The swelling index was calculated as per below equation:
Moisture loss is crucial to ensure product stability and efficacy during storage as excessive moisture loss can alter the flexibility, adhesive properties, and mechanical integrity of ocuserts, which further leads to ineffective drug delivery. The test also helps in determining the storage conditions and influences the packaging design to protect ocuserts from moisture fluctuations (Farahmandnejad et al., 2024). The prepared SCM and GSM ocuserts were initially weighed and kept in desiccator. Desiccator was previously sterilized by saturation using ethanol:acetone (60:40). The desiccator was filled with anhydrous calcium chloride to absorb moisture. After 36 hours, the ocuserts were taken out and re-weighed (Nagpal et al., 2021). The percentage moisture loss of the prepared ocuserts was calculated as per below equation:
The prepared SCM and GSM ocuserts were placed separately in 5 mL of freshly prepared phosphate buffer of pH 7.4 and crushed to extract the drug. After this, the solution containing crushed ocuserts was placed in the shaking orbital incubator (Lafco India Scientific Industries, Mumbai, India) for 24 hours to extract out the maximum drug loaded in ocuserts (Nagpal et al., 2021). The drug concentration was analytically determined using the HPLC analytical method after suitable dilutions (Sun et al., 2017).
The sterility testing was performed in accordance with the procedure outlined in the United States Pharmacopeia (USP) <71> guidelines. Before performing the sterility test, the prepared SCM and GSM ocuserts were sterilized under ultraviolet radiations. The thioglycolate broth media (for anaerobic bacteria presence) and soyabean casein digest media (for aerobic bacteria and fungus presence) were chosen to evaluate the sterility of ocuserts. For culturing, E. coli bacteria was selected as it is an anaerobic bacterium which is capable of surviving in both aerobic and anaerobic conditions and is easily available. For fungus growth, Candida albicans was used as it is facultative anaerobic in nature and easily available. Total 18 petri dishes were used for study, which were labeled as below (Hady et al., 2024):
- 1)
6 petri dishes were labeled as “negative,” containing only the prepared medium.
- 2)
6 petri dishes were labeled as “positive,” containing the medium mixed with bacteria (E. coli) and fungus (Candida albicans).
- 3)
6 petri dishes were labeled as “test,” containing only prepared ocuserts on the same medium.
All the above sterility procedures were performed in aseptic conditions under laminar air flow (Teba et al., 2024).
International Council for Harmonization of Technical Requirements for Pharmaceuticals for Human Use (ICH) Q1A(R2) guidelines and Matthews et al. (2000) were followed for performing the stability studies in ocuserts. Prepared ocuserts were placed in a sterile glass petri plate and stored in stability chamber at 40±2 °C temperature and 75±5 % relative humidity. After predefined time intervals, that is, 0, 7, 15, 21, 30, 60, 90, 120, 150, and 180 days, the ocuserts were taken out from the stability chamber and further tested for percentage drug content (Nagpal et al., 2021). For drug content calculations, the HPLC analytical method was used (Sun et al., 2017).
In vitro drug release study was performed using Franz diffusion cell apparatus. Simulated tear fluid (STF) media of pH 7.4 was freshly prepared and used for further dilutions while sampling. Simulated tear fluid (STF) is a composition of accurately weighed 0.67 g of sodium chloride, 0.20 g of sodium bicarbonate, and 0.08 g of calcium chloride, which are dissolved in 100 ml distilled water (Xu et al., 2023). Dialysis membrane number 150 (HiMedia Laboratories, Mumbai, India) was selected as a semi-permeable membrane (SPM), which is a cellulose-based membrane having molecular weight cut-off (MWCO) of approximately 12,000–14,000 daltons. SPM was sandwiched between the donor and receptor compartments of Franz diffusion cell. Prepared ocusert (1 mg) was placed over the SPM in donor compartment along with 2 ml of STF at 37±0.5 °C (Hady et al., 2024). The receptor environment was allowed to stir using magnetic stirrer with 100 rpm at room temperature. After predefined time intervals (1, 2, 4, 6, 8, 10, 12, 14, 16, 18, 20, 22, 24, 26, and 28 days), 0.5 ml of solvent was taken out from the receptor environment and was replaced with 0.5 ml of STF to maintain the sink conditions (Teba et al., 2024). The amount of drug release from both the prepared SCM and GSM ocuserts was analyzed using the HPLC analytical method after suitable dilutions (Sun et al., 2017).
The prepared SCM and GSM ocuserts were found to have good texture and smooth surface without any visible cracks and discoloration (Figure 2).

Prepared SCM and GSM ocuserts.
The surface pH of prepared SCM (6.88±0.24) and GSM (6.90±0.28) ocuserts are closer to the ideal pH range of 6.7–7.4 and were found to be suitable for ophthalmic use (Teba et al., 2024).
The thickness of SCM ocuserts (0.47±0.10 mm) were found to be higher than that of GSM ocuserts (0.29±0.03 mm). This may be because the SCM ocuserts were prepared using DRM and RCM in which DRM was sandwiched between two RCMs. The thickness observed in both ocuserts was found to be ideal for ophthalmic use.
The folding endurance of prepared ocuserts was found to be directly proportional to the thickness of ocuserts. The SCM ocuserts showed the folding endurance of 87.17±4.34 folds, while GSM ocuserts showed it as 71.33±4.82 folds.
The average weight of SCM ocuserts was found to be 7.83±0.38 mg, which was greater than the GSM ocuserts 6.55±0.76 mg. Both the weights (SCM and GSM ocuserts) were found to be suitable for ophthalmic use.
The swelling index of SCM and GSM ocuserts was found to be different depending on the weight of ocuserts. The swelling index of SCM ocuserts was found to be 6.69±0.33 %, and for GSM ocuserts, it was found to be 5.40±0.27 %. Both the ocuserts showed swelling index less than 10% and hence were found to be suitable for ophthalmic use.
The percentage loss of SCM and GSM ocuserts was calculated to check if the ocuserts will remain stable while transporting in dry conditions. The prepared SCM ocuserts showed the moisture loss of 4.38±0.37 % when stored in the desiccator for about 48 hours and GSM ocuserts showed 7.38±0.46 %. Both ocuserts did not show any sign of brittleness, but the moisture loss of GSM ocuserts was found higher than the ideal range which should not be more than 5%. Hence, SCM ocuserts perform better during storage, while the GSM ocuserts may require specialized packaging to prevent moisture loss.
The prepared SCM and GSM ocuserts were evaluated for uniformity in drug content. The SCM ocuserts were found to retain higher amount of BT as compared to the GSM ocuserts. The drug content in SCM ocuserts was found to be 88.26±3.33%, while for GSM ocuserts, it was found to be 74.91±4.39%.
After 7 days of incubation, the results (Figure 3) confirmed that the prepared SCM and GSM ocuserts were sterilized in nature without any microbial and fungal contamination. Table 1 shows the result obtained after 7 days of all labeled petri dishes.
Sterility testing of prepared ocuserts after 7 days of incubation.
Different petri dishes used in sterility testing and the conclusion.
| Petri dishes used (n=6) | Type | Purpose | Result | Conclusion |
|---|---|---|---|---|
| Negative control | Medium only | To confirm sterility of medium prepared | No microbial and fungal growth seen in the petri dish | Prepared media was found to be sterile |
| Positive control | Medium containing bacteria and fungi | To confirm suitability of medium for growth of micro-organisms | Positive growth seen in the petri dish | Prepared media was suitable for microbial growth |
| Test control | Medium containing prepared ocuserts | To confirm sterility of prepared SCM and GSM ocuserts | No microbial and fungal growth seen in the petri plate | Prepared ocuserts were found to be sterile in nature |
The drug content of SCM and GSM ocuserts was calculated using HPLC analytical methods at different time intervals. Initial drug content of prepared SCM ocuserts was found to be 88.26±3.33 %, while for GSM ocuserts, it was found to be 74.91±4.39 %. After 180 days, the result showed lowering of drug content in ocuserts prepared by both SCM and GSM methods. However, the reduction in drug content for SCM ocuserts was found to be lower (3.62% of its initial value) compared to GSM ocuserts (14.75% of its initial value). Table 2 shows the drug content obtained at different time intervals for both SCM and GSM ocuserts.
Drug content obtained at different time intervals.
| Stability conditions | Time interval (in days) | Percentage drug content (n=6) for SCM ocuserts | Percentage drug content (n=6) for GSM ocuserts |
|---|---|---|---|
| 40±2 °C / 75±5 % RH | 0 | 88.26±3.33 | 74.91±4.39 |
| 7 | 88.15±3.31 | 73.25±2.32 | |
| 15 | 87.76±3.53 | 72.36±2.54 | |
| 21 | 87.39±2.53 | 71.93±1.55 | |
| 30 | 87.08±3.49 | 71.08±2.64 | |
| 60 | 86.83±2.45 | 69.93±2.71 | |
| 90 | 86.36±2.87 | 68.76±1.75 | |
| 120 | 86.05±2.24 | 67.05±2.55 | |
| 150 | 85.91±2.83 | 65.59±1.78 | |
| 180 | 85.06±2.05 | 63.86±1.95 |
The comparative table of results obtained from all the above tests (physical appearance, surface pH, uniformity of thickness, folding endurance, weight variation, swelling index, percentage moisture loss, uniformity of drug content) for both SCM and GSM ocuserts are shown in Table 3.
Comparison of evaluation tests for SCM and GSM ocuserts.
| Evaluation tests | SCM ocuserts | GSM ocuserts | Standard value | References |
|---|---|---|---|---|
| Physical appearance | Smooth, no roughness without visible crack | Smooth, no roughness without visible crack | Smooth, no cracks | (Hady et al., 2024) |
| Surface pH | 6.88±0.24 | 6.90±0.28 | 6.7–7.4 | (Teba et al., 2024) |
| Uniformity of thickness | 0.47±0.10 mm | 0.29±0.03 mm | 0.20–1.0 mm | (Mahajan et al., 2015) |
| Folding endurance | 87.17±4.34 folds | 71.33±4.82 folds | 75–110 folds | (Farahmandnejad et al., 2024) |
| Weight variation | 7.83±0.38 mg | 6.55±0.76 mg | 5–10 mg | (Farahmandnejad et al., 2024) |
| Swelling index | 6.69±0.33 % | 5.40±0.27 % | Less than 10 % | (Koutsoviti et al., 2021) |
| Percentage moisture loss | 4.38±0.37 % | 7.38±0.46 % | Less than 5 % | (Tundisi et al., 2021) |
| Uniformity of drug content | 88.26±3.33 % | 74.91±4.39 % | No specified limit | (Bhabani et al., 2015) |
In vitro drug release study was conducted for both prepared SCM and GSM ocuserts for about 28 days. The results showed that the prepared SCM ocuserts showed better controlled drug release compared to GSM ocuserts. Comparison of in vitro drug release study of prepared SCM and GSM ocuserts is shown in Figure 4. The controlled release of ocuserts is mainly because of the presence of ethyl cellulose (EC) containing RCM membranes. Ethyl cellulose is hydrophobic in nature so water penetration through membrane is minimal which result in slow swelling of ocuserts. The controlled release of drug from ocuserts occurs through diffusion mechanisms where the drug diffused out from higher concentration to lower concentration till its complete release. The EC used in RCM is resistant to hydrolysis and hence showed slow breakdown in presence of lacrimal enzymes and water. This results in extended release of drug from ocuserts (from days to months). SCM showed better controlled release (28 days) compared to GSM ocuserts (16 days) which can be because of difference in thickness of SCM and GSM ocuserts. The GSM ocuserts were found to be thinner (0.29±0.03 mm) compared to SCM ocuserts (0.47±0.10 mm). SCM ocuserts have upper and lower RCM which further inhibit the faster release of entrapped drug. This leads to slower drug release from SCM ocuserts as compared to GSM ocuserts. The study was conducted for 28 days for both SCM and GSM ocuserts. However, GSM ocuserts reach the steady state after 16 days, while the SCM ocuserts reach the steady state after 28 days. The results confirmed that GSM ocuserts can be used for short-term treatment of eye diseases like dry eyes and acute ocular hypertension. While SCM ocuserts can be used for chronic eye diseases requiring long-term therapy like glaucoma. The GSM ocuserts can show enhanced drug release depending on film uniformity and thickness.

Comparison of in vitro drug release study of prepared SCM and GSM ocuserts.
A statistical analysis using a Student’s t-test was conducted to compare the drug release profiles of SCM and GSM ocuserts. The results demonstrated a significant difference between the release pattern of SCM and GSM ocuserts, with a p-value less than 0.05. These findings support the conclusion that SCM ocuserts exhibit superior sustained-release properties compared to GSM ocuserts.
In current research work, we have prepared BT-loaded PLGA ocuserts using SCM and GSM. The prepared SCM and GSM ocuserts were further assessed using different evaluation tests. The appearance and pH of both the ocuserts were found to be within ideal range which confirms that the ocuserts prepared by both these methods do not cause any pH or shape-related eye irritation effects. The thickness of the SCM ocuserts (0.47±0.10 mm) was found to be higher compared to that of the GSM ocuserts (0.29±0.03 mm). This may be because the DRM is sandwiched between two RCMs in the case of SCM ocuserts, resulting in greater thickness (Kumar et al., 2022). The folding endurance of SCM ocuserts (87.17±4.34 folds) was found to be higher compared to that of GSM ocuserts (71.33±4.82 folds) because of the more thickness of the SCM ocuserts (Abdul et al., 2011). Weight variation of SCM ocuserts (7.83±0.38 mg) was found to be higher than that of GSM ocuserts (6.55±0.76 mg), which may be because of three film layers of DRM and RCM used in SCM ocuserts (Kumar et al., 2022). Swelling index of the SCM ocuserts (6.69±0.33 %) was also found to be higher compared to that of GSM ocuserts (5.40±0.27 %) (Nagpal et al., 2021). Swelling index is an important parameter to check the impact of environmental conditions such as temperature and humidity during transportation and storage in ocuserts. Films with a high swelling index, on one hand, have the ability to absorb more moisture from the environment, which may further lead to change in ocusert shape and its adherence ability to ocular surface. On the other hand, the ocuserts with low swelling may dry out, potentially reducing their effectiveness. So, it should be in an ideal range (5–10% for ocular preparations) to ensure effectiveness of prepared formulation (Farahmandnejad et al., 2024). All the above obtained results confirmed the suitability of both GSM and SCM ocuserts for ophthalmic use.
The moisture loss of the prepared SCM ocuserts was found to be 4.38±0.37%. However, for GSM ocuserts, it was found to be more than 5% (7.38±0.46 %). This lack of RCM covering over GSM ocuserts may be the reason behind higher moisture loss (Kumar et al., 2022). Ocuserts are sensitive to moisture loss as well because with excessive dehydration, ocuserts may lead to brittleness and flexibility. Loss of moisture becomes important field to evaluate the behavior of films during transportation and storage. Ocuserts with high moisture loss will additionally require proper storage in airtight packaging and stable humidity levels in order to maintain the moisture balance of ocuserts (Farahmandnejad et al., 2024). The drug content of the SCM ocuserts (88.26±3.33 %) was found to be higher as compared to that of the GSM ocuserts (74.91±4.39 %). Both the ocuserts were found to be sterile in nature during use with absence of fungal and bacterial contamination (Kumar et al., 2022). Stability studies confirmed that the SCM ocuserts were more stable as compared to the GSM ocuserts. After 6 months, the SCM ocuserts showed 85.06±2.05% of drug content, while the GSM ocuserts showed 63.86±1.95% of drug content (Nagpal et al., 2021). Stability studies of ocular formulations are important to evaluate the performance and integrity under various conditions like temperature and humidity over an extended period. If the films maintain their structural integrity and consistent drug content throughout the study, this indicates good stability and suggests a longer shelf-life of formulation. Minimal degradation would imply that films can withstand typical storage conditions like room temperature and sealed packaging, without significant performance deterioration. On the other hand, if significant decline in drug content and other stability parameters, such as swelling, moisture loss, or changes in drug release rates, is observed under accelerated conditions, it indicates the need for proper storage of ocuserts under more stringent storage requirements, such as refrigeration or desiccant packaging.
The in vitro drug release study of the prepared SCM ocuserts showed a better controlled release compared to GSM ocuserts. SCM ocuserts showed drug release till 28 d before reaching to the steady state. However, the GSM ocuserts reached steady state within 16 d. More polymeric coverings in the SCM ocuserts result in better controlled release compared to GSM ocuserts (Mealy et al., 2014). When we compare the real-word feasibility of both SCM and GSM methods, SCM is particularly beneficial for large-scale production due to its ability to fabricate multiple ocuserts in one batch, which further offers better control over polymeric concentration and its solvent evaporation. This further results in improved uniformity in film thickness and drug release profiles, making it suitable for industrial applications. However, SCM requires specialized equipment for solvent handling and drying control, and considering this is used for ophthalmic applications, maintaining sterility throughout the process becomes a significant challenge. On the other hand, GSM is better suited for small-scale, high-precision manufacturing, especially where stringent sterility control is required. The use of contained glass molds minimizes contamination risks, but the method is less efficient for large-scale production because of labor-intensive processes and lower batch output. Additionally, GSM may exhibit high variation in film thickness due to manual handling. Economically, SCM is more cost-effective for large-scale production, though it necessitates solvent recovery systems to comply with environmental and regulatory standards. In contrast, GSM, while reducing solvent exposure, is more expensive due to higher labor costs and lower production efficiency. Future research may explore hybrid techniques combining the sterility benefits of GSM with the scalability of SCM.
The ocuserts were successfully prepared using SCM and GSM methods. Although most of the results confirmed that both the prepared ocuserts were ideal to be used for ophthalmic use, in vitro drug release, drug content, stability studies, and moisture loss confirmed that the SCM method of preparation of ocuserts is better than the GSM method. GSM-based ocuserts are suitable for high-precision, small-scale applications. Maintenance of sterility for GSM ocuserts is easier compared to SCM. The GSM method for preparation of ocuserts allows easy handling and removal of film without any damage in its structure. The technique is good enough to facilitate the formation of thin, flexible films. The use of smooth and nonstick glass surface ensures the uniform drug distribution within the film and its improved consistency in drug release. However, GSM limits its use for large-scale manufacturing. On the other hand, SCM-based ocuserts showed better controlled release when compared with GSM ocuserts. This confirmed that the SCM ocuserts can be more beneficial for chronic eye diseases such as glaucoma and diabetic retinopathy (DR) which require long-term therapies. While GSM-based ocuserts are more suitable for short treatment of eye diseases like dry eyes and acute hypertension, SCM-based ocuserts showed better stability profile and swelling index which confirmed its better stability during storage and transportation. This study demonstrates that SCM ocuserts exhibit superior drug entrapment efficiency, folding endurance, and sustained release compared to GSM ocuserts, making SCM a more suitable approach for ophthalmic drug delivery. However, further research is needed to address biocompatibility concerns, ensure long-term ocular tolerance, and validate the findings through in vivo pharmacokinetic studies. The study conducted was limited to in vitro evaluation. The future research of the study may include the ex vivo drug release study of using porcine cornea and their comparison. Moreover, in-vivo testing of prepared ocuserts and their efficacy of control increased intraocular pressure can be potential future prospective of this study. Future studies should also explore hybrid fabrication methods that combine the sterility benefits of GSM with the scalability of SCM. Additionally, optimizing the polymer composition and cross-linking strategies could further enhance the ocuserts’ performance. If successfully translated into clinical settings, SCM-based ocuserts could revolutionize glaucoma management by reducing dosing frequency and improving patient adherence.